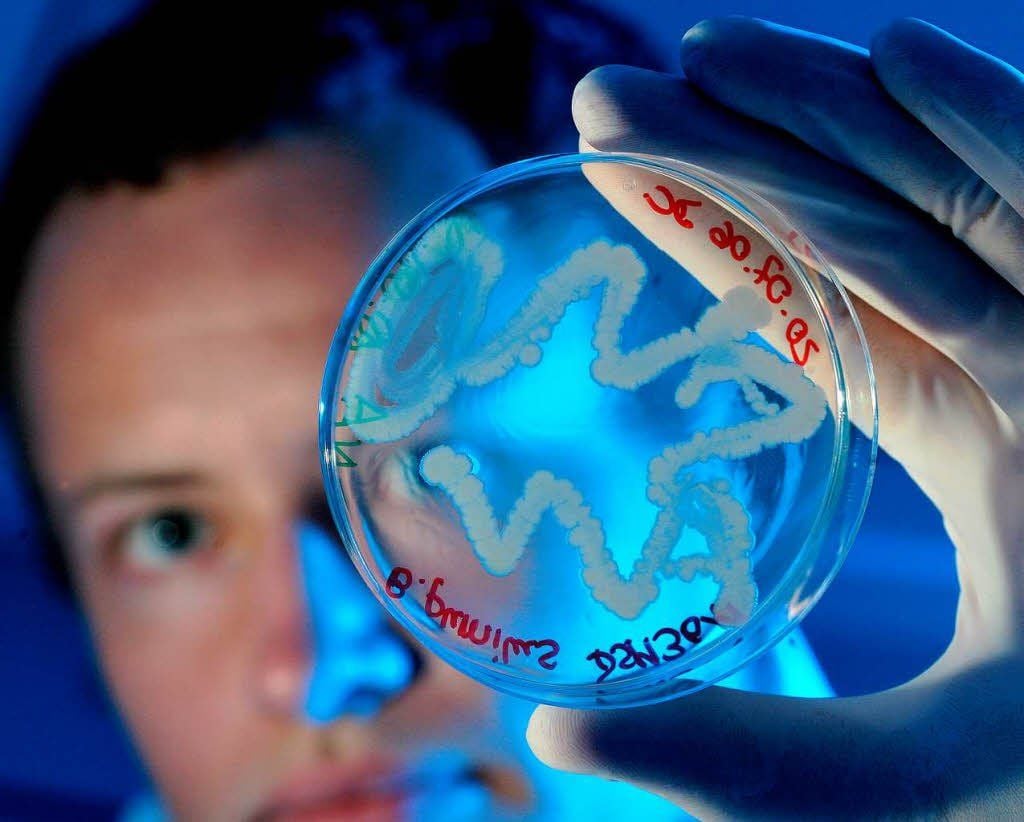

Viagra, Penicillin... Viagra, Penicillin...: Per Zufall: Diese Dinge wurden nebenbei erfunden

Halle (Saale)/DMN. - Ohne diese wissenschaftliche Panne wären viele Menschen an Infektionen gestorben: Der schottische Bakteriologe Alexander Fleming ließ 1928 während des Sommerurlaubs eine seiner Proben im Labor stehen. So landeten Pilzsporen von draußen auf der Versuchskultur mit Bakterien - sie verschimmelte. Eigentlich ganz schön schlampig für einen Forscher. Aber als Fleming aus dem Urlaub zurückkehrte, entdeckte er, dass der Schimmelpilz die Bakterien in der Glasschale vernichtet hatte. Der Forscher hatte also ein Mittel gegen bakterielle Erkrankungen gefunden.
Daraus entwickelten Flemings Kollegen wenig später eines der wichtigsten Arzneiwirkstoffe der Welt: das Penicillin. Als Lohn für die Erfindung des ersten Antibiotikums gab es 1945 den Nobelpreis.
Ebenfalls heilsam ist das Potenzmittel Viagra mit dem Wirkstoff Sildenafil. Ursprünglich sollte es aber nicht die Potenz steigern, sondern Männern und Frauen mit Bluthochdruck und Herzbeschwerden helfen. Zwar waren alle Testergebnisse enttäuschend, dafür zeigten sich unerwartete Nebenwirkungen: Männliche Versuchspersonen, die die Pillen eingenommen hatten, bekamen viel leichter Erektionen als vorher. 1998 erhielt das US-Unternehmen Pfizer von der Gesundheitsbehörde die Genehmigung, Viagra zu verkaufen: Der Erfolg der Pille hält bis heute an.
Lesen Sie auf den nächsten Seiten, welche genialen Produkte wir ebenfalls dem Zufall verdanken.
Nächste Seite: Was ein geschmolzener Schokoriegel ermöglichte
Was ein geschmolzener Schokoriegel ermöglichte
Ingenieur Percy Spencer arbeitete in den 1940er Jahren für die US-Firma Raytheon - in einem militärischen Forschungslabor. Spencer entwickelte Mikrowellenstrahlen (Magnetronen), mit denen amerikanische Kampfflugzeuge Radarwellen erzeugen konnten. Damit wollten die Allierten russische Flugzeuge aufspüren. Als sich Spencer während der Arbeit einem Magnetron näherte und in seiner Hosentasche ein Schokoriegel schmolz, kam dem Radartechniker eine Idee: Der erste Mikrowellenherd wurde 1947 produziert.
Mit einer anderen Art von Strahlung experimentierte rund 50 Jahre zuvor Wilhelm Conrad Röntgen: Der deutsche Physiker testete nachts in seinem Labor Elektronenstrahlen, die gerade erfunden worden waren. Röntgen beobachtete, dass die mit Pappe abgedeckte Strahlenquelle fluoreszierende Gegenstände zum Leuchten brachte.
Der Forscher bat seine Frau daraufhin, ihre Hand auf eine Fotoplatte zu legen, und ließ diese durchleuchten: Die erste Röntgenaufnahme von der Hand samt Ehering wurde weltberühmt, und die Strahlen tragen seitdem seinen Namen. 1901 bekam Röntgen den Nobelpreis.
Nächste Seite: Einfach auf die heiße Herdplatte gefallen
Einfach auf die heiße Herdplatte gefallen
Gummi war lange Zeit ein äußerst empfindlicher Stoff: Bei Wärme schmolz und bei Kälte brach das Material. Jahrelang arbeitete der Chemiker Charles Nelson Goodyear daran, Naturkautschuk durch chemische Zusätze haltbarer zu machen. Doch der US-Amerikaner kam einfach nicht weiter - bis ihm 1839 ein Stück Kautschuk-Schwefel-Gemisch auf eine heiße Herdplatte fiel. Die Masse war auf einmal nicht mehr feucht und klebrig, sondern dauerhaft elastisch, robust und stabil. Goodyear hatte die so genannte Vulkanisation entdeckt, und damit das Hartgummi.
Auch Teflon wurde durch solch einen Zufall erfunden. Eigentlich suchte der US-amerikanische Chemiker Roy J. Plunkett in den späten 1930er Jahren ein neues Kühlmittel. Dazu verwendetet er das Gas Tetrafluorethylen (TFE). Aus Sparsamkeit bestellte Plunkett gleich 50 Flaschen des Gases. Und eine dieser Flaschen lagerte so lange, bis sich das Gas von selbst polymerisierte, also chemisch reagierte. Es entstand eine Substanz, die sehr glatt und hitzebeständig ist: Das Teflon. Bis zur Antihaftschicht-Pfanne war der Weg nun nicht mehr mehr.
Neben Teflonpfannen findte man auch Porzellan in jeder Küche - erfunden wurde es im 7. Jahrhundert in China. In der frühen Neuzeit war Porzellan in Europa sehr begehrt, weil die Herstellungsweise dort noch unbekannt war. Alchemist Johann Friedrich Böttger sollte eigentlich für Sachsens Kurfürst Silber in Gold verwandeln. In Versuchen mischte Böttger Tonerde mit Feldspat, Quarz und Wasser und brannte das Gemisch - heraus kam Porzellan. 1710 wurde in Meißen die erste Manufaktur eingerichtet.
Nächste Seite: Erst ein Gewitter, dann das Quecksilber
Erst ein Gewitter, dann das Quecksilber
Vorläufer der Fotokamera ist die seit Jahrhunderten bekannte Camera Obscura - aber ihre Bilder wurden nur flüchtig erzeugt. Deshalb suchte Maler Louis-Jacques Mandé Daguerre 1837 nach einem Verfahren, um die Bilder dauerhaft festzuhalten. Daguerre hatte bereits herausgefunden, dass Bilder auf lange belichteten Silberplatten für eine kurze Zeit sichtbar blieben. Bei Versuchen im Freien überraschte ihn ein Gewitter - der Künstler legte eine belichtete Platte in einen Laborschrank. Am nächsten Tag stellte er fest, dass das Bild noch erkennbar war: Zufällig lagerten Quecksilberkügelchen mit im Schrank. Die Daguerrotypie war erfunden, sie gilt als erstes praktikables fotografisches Verfahren.
Auch bei der Entdeckung des Filmstreifens spielte der Zufall mit: Der schwäbische Physiker und Chemiker Christian Friedrich Schönbein verschüttete um 1846 bei Experimenten in seiner Küche Schwefel- und Salpetersäure. Mit der Baumwollschürze seiner Frau wischte Schönbein die Bescherung auf. Doch als er die Schütze über dem Ofen aufhängte, ging der Stoff in Flammen auf und verpuffte. Per Zufall hatte Schönbein Zellulosenitrat (Schießbaumwolle) entdeckt, aus dem später das Zelluloid für Filmstreifen entwickelt wurde.
Ein Licht ging auch dem US-amerikanischen Chemiker Russell S. Ohl auf, als er 1940 im Labor der Telefonfirma Bell die Leitfähigkeit von Silizium-Halbleitern erforschte. Dabei beobachtete er, dass sich ihr Widerstand unter Lichteinwirkung änderte: Durch die Beleuchtung des Siliziums konnte ein Strom erzeugt werden. Damit legte Ohl den Grundstein für die Entwicklung der Photovoltaik-Zelle - der Solarzelle, wie wir sie heute kennen.
Nächste Seite: Von Pflastern und praktischen Lesezeichen
Von Pflastern und praktischen Lesezeichen
Forscher der Hamburger Firma Beiersdorf suchten in den 1930er Jahren nach einem hautverträglichen Klebstoff für Pflaster. Allerdings geriet der Kleber zu fest - also wollten die Erfinder daraus Gewebeband herstellen. Als günstiges Trägermaterial bot sich 1935 Zellophan an - und plötzlich war der durchsichtige Klebestreifen geboren. Heute ist er vor allem unter dem Markennamen Tesafilm bekannt.
Ebenfalls klebrig und praktisch fürs Büro sind die kleinen Post-its. Entscheidend für die Erfindung der Klebezettel war ein Superkleber, den Chemiker Spencer Silver 1968 für die Minnesota Mining and Manufacturing Company (3M) entwickeln wollte. Der Klebstoff ließ sich rückstandslos entfernen. Zunächst wusste keiner, was man damit anfangen könnte. Jahre später suchte Silvers Kollege Art Fry ein Lesezeichen für die Liederbücher im Kirchenchor. Ihn nervte, dass die Lesezeichen immer herunterfielen. Fry holte eine Probe des Klebers aus dem Labor und trug ihn auf kleine Zettel auf - so war 1974 das Post-it geboren.
Genauso ein Versehen war der Vorläufer des Teebeutels vor dem Ersten Weltkrieg. Der US-amerikanische Teehändler Thomas Sullivan verschickte Teeproben an Kunden. Dazu füllte er sie in kleine Seidenbeutel ab – eigentlich nur zum Transport. Doch die Empfänger nutzten die kleinen Beutel so, wie wir es heute kennen: Sie glaubten, dass dies so von Sullivan gedacht gewesen sei. Praktischerweise mussten die losen Teeblätter nicht aus der Kanne entfernt werden, und man brauchte kein Teesieb. Der heutige Teebeutel aus Filterpapier wurde 1929 von Adolf Rambold für die Dresdner Firma Teekanne erfunden.
Nächste Seite: Das heilsame Glibberzeug am Bohrturm
Das heilsame Glibberzeug am Bohrturm
Der aus Großbritannien stammende Chemiker Robert Chesebrough machte sein Geschäft zunächst in New York, er destillierte Petroleum aus dem Öl von Pottwalen. 1859 ging er nach Titusville. Dort war eine Petroleum-Quelle entdeckt worden, was sein Geschäft zunichte machte. Chesebrough wollte nach neuen Materialien aus dem Brennstoff forschen - dabei fiel ihm an den Bohrtürmen eine Schmierschicht auf. Niemand wusste genau, was das für ein Glibberzeug war, aber es heilte offenbar Wunden. Der neugierige Geschäftsmann untersuchte die Schmiere genauer - und verkaufte das Petroleum-Gelee später in gereinigter Form als Vaseline.
Der Zufall verhalf auch Chemiker Albert Hofmann zu einer verrückten Erfindung. Der Schweizer forschte 1938 am Getreidepilz Mutterkorn - er suchte einen Wirkstoff zur Stimulation des Blutkreislaufs. Bei seinen Versuchen synthetisierte Hofmann erstmals Lysergsäurediethylamid (LSD) und testete es an Tieren, aber die erhoffte Wirkung trat nicht ein. 1943 testete er LSD erneut und nahm unbeabsichtigt etwas zu sich, woraufhin eine halluzinogene Wirkung eintrat. In den 50er Jahren wurde LSD in der Psychiatrie eingesetzt – und später eine populäre Droge der Hippiebewegung, bis es 1966 in den USA verboten wurde. (gs)